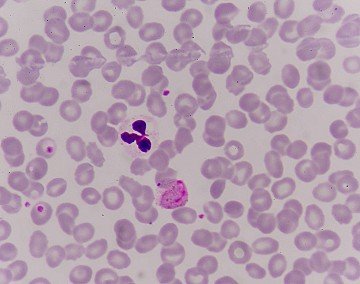
Press Release cover image

Compatibilità
Salva(0)
One Project Technical Support vacancy in a research project in the Parasite Cell Biology Group at International Centre for Genetic Engineering and Biotechnology (ICGEB), New Delhi
Duty Station: New Delhi, India
Closing date: 31-Oct-2025
Interested candidates can apply by sending their curriculum vitae with details of their
scientific experience to: [email protected] by 31st October, 2025.
Please mention “Application for Project Technical Support-I position” in the subject of the email.
For educational qualifications and other details, please refer to the detailed advertisement here:
Rayies Altaf